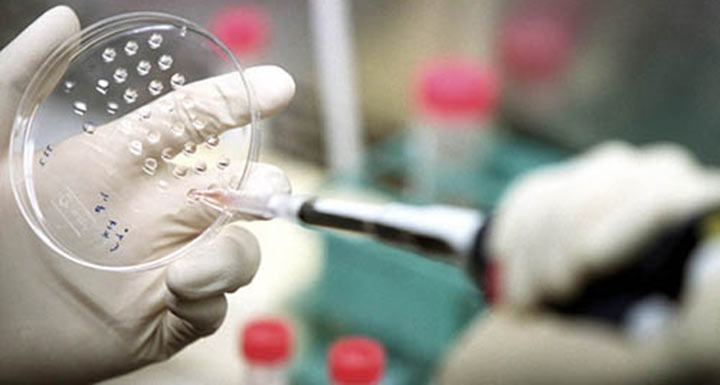

Why we allow Big pharma to rip us off
According to a new federal database put online last week, pharmaceutical companies and device makers paid doctors some $380 million in speaking and consulting fees over a five-month period in 2013.
Some doctors received over half a million dollars each, and others got millions of dollars in royalties from products they helped develop.
Doctors claim these payments have no effect on what they prescribe. But why would drug companies shell out all this money if it didn’t provide them a healthy return on their investment?
America spends a fortune on drugs, more per person than any other nation on earth, even though Americans are no healthier than the citizens of other advanced nations.
Of the estimated $2.7 trillion America spends annually on health care, drugs account for 10 percent of the total.
Government pays some of this tab through Medicare, Medicaid, and subsidies under the Affordable Care Act. But we pick up the tab indirectly through our taxes.
We pay the rest of it directly, through higher co-payments, deductibles, and premiums.
Drug company payments to doctors are a small part of a much larger strategy by Big Pharma to clean our pockets.
Another technique is called “product hopping” —making small and insignificant changes in a drug whose patent is about to expire, so it’s technically new.
For example, last February, before its patent expired on Namenda, its widely used drug to treat Alzheimer’s, Forest Laboratories announced it would stop selling the existing tablet form of in favor of new extended-release capsules called Namenda XR.
The capsules were just a reformulated version of the tablet. But even the minor change prevented pharmacists from substituting generic versions of the tablet.
Result: Higher profits for Forest Labs and higher costs for you and me.
Another technique is for drug companies to continue to aggressively advertise prescription brands long after their twenty-year patents have expired, so patients ask their doctors for them. Many doctors will comply.
America is one of few advanced nations that allow direct advertising of prescription drugs.
A fourth tactic is for drug companies to pay the makers of generic drugs to delay their cheaper versions. These so-called “pay-for-delay” agreements generate big profits for both the proprietary manufacturers and the generics. But here again, you and I pay. The tactic costs us an estimated $3.5 billion a year.
Europe doesn’t allow these sorts of payoffs, but they’re legal in the United States because the major drug makers and generics have fought off any legislative attempts to stop them.
Finally, while other nations set wholesale drug prices, the law prohibits the U.S. government from using its considerable bargaining power under Medicare and Medicaid to negotiate lower drug prices. This was part of the deal Big Pharma extracted for its support of the Affordable Care Act of 2010.
The drug companies say they need the additional profits to pay for researching and developing new drugs.
But the government supplies much of the research Big Pharma relies on, through the National Institutes of Health.
Meanwhile, Big Pharma is spending more on advertising and marketing than on research and development – often tens of millions to promote a single drug.
And it’s spending hundreds of millions more every year lobbying. Last year alone, the lobbying tab came to $225 million, according to the Center for Responsive Politics.
That’s more than the formidable lobbying expenditures of America’s military contractors.
In addition, Big Pharma is spending heavily on political campaigns. In 2012, it shelled out over $36 million, making it the biggest political contributor of all American industries.
Why do we put up with this? It’s too facile to say we have no choice given how much the industry is spending on politics. If the public were sufficiently outraged, politicians and regulatory agencies wouldn’t allow this giant ripoff.
But the public isn’t outraged. That’s partly because much of this strategy is hidden from public view.
But I think it’s also because we’ve bought the ideological claptrap of the “free market” being separate from and superior to government.
And since private property and freedom of contract are the core of the free market, we assume drug companies have every right to charge what they want for the property they sell.
Yet in reality the “free market” can’t be separated from government because government determines the rules of the game.
It determines, for example, what can be patented and for how long, what side payoffs create unlawful conflicts of interest, what basic research should be subsidized, and when government can negotiate low prices.
The critical question is not whether government should play a role in the market. Without such government decisions there would be no market, and no new drugs.
The issue is how government organizes the market. So long as big drug makers have a disproportionate say in these decisions, the rest of us pay through the nose.
(From the: Robert Reich)
